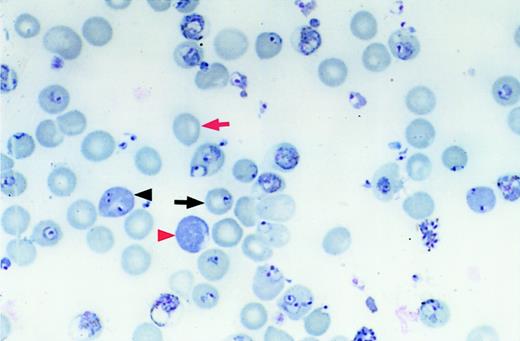
Fig. 1. Measuring infection of reticulocytes and normocytes. / Differential counts of erythrocyte types were performed by counting the number of infected normocytes (black arrow), uninfected normocytes (red arrow), infected reticulocytes (black arrowhead), and uninfected reticulocytes (red arrowhead). Original magnification, × 1000; stain, Wright-Giemsa.

Abstract
Erythrocyte invasion by malaria parasites is a complex multistep process involving parasite and erythrocyte receptors. It is a critical stage in the parasite life cycle and, therefore, a logical step in which to intervene to prevent or ameliorate disease. Rodent models of malaria, commonly Plasmodium yoelii, are frequently used for studies of malaria pathogenesis. Little is known, however, about the invasion machinery of rodent malaria parasites. We have found previously that mice congenic for a region of chromosome 1, containing the Duffy antigen/receptor for chemokines (DARC), have different susceptibility to P yoelii infection. Because P vivax, a human parasite, and P knowlesi, a simian parasite, use DARC to enter human erythrocytes, we sought to identify the role of the murine DARC in P yoelii invasion. Using a novel in vivo invasion assay and DARC knock-out mice, we found that DARC knock-out normocytes (mature erythrocytes) had negligible levels of P yoelii invasion compared with wild-type normocytes, demonstrating that DARC is a receptor for invasion of murine erythrocytes. In contrast, DARC knock-out reticulocytes were invaded at a rate similar to that for wild-type reticulocytes. We conclude that there is a DARC- independent pathway for reticulocyte invasion. These findings represent the first identification of a murine malaria receptor on erythrocytes and the first determination that different pathways of invasion exist on normocytes and reticulocytes. Because we show conservation of host–receptor interactions between rodent and human malaria, we can now use this model to identify how immunity can interfere with the invasion process.
Introduction
Malaria infects 300 to 500 million people and causes 1 to 2 million deaths, mostly of children, per year. The goal of researchers in the field of malaria pathogenesis is to prevent or ameliorate disease through vaccines or through pharmaceutical intervention. This requires a detailed understanding of the molecular interactions essential to parasite propagation or survival. All the morbidity and mortality of malaria infection occurs during the erythrocyte stage of the life cycle. Because the erythrocyte stage requires entry of free merozoites, the invasive stage of the parasite, into RBCs, erythrocyte invasion is a logical step of the parasite life cycle in which to intervene. Before interventional strategies can be approached logically, the essential features of invasion must be identified.
Parasite entry into erythrocytes is a complex multistep process. Electron microscopy studies have shown that invasion involves parasite attachment, reorientation of the parasite's apical end toward the erythrocyte, formation of a junction between the parasite and the RBC membrane, and internalization of the parasite.1,2 Although it is clear that molecules on both the parasite and the erythrocyte surface mediate this process,3-15 the exact nature of the molecules involved in each morphologic step is unknown. The human malaria parasite, Plasmodium vivax, and the simian parasite,P knowlesi, use the Duffy antigen/receptor for chemokines (DARC) as a receptor for erythrocyte invasion.6,10-13,16-18 DARC is a promiscuous chemokine receptor expressed on the surfaces of human and other mammalian erythrocytes.19 Unlike P vivax, which has an absolute requirement for DARC, P knowlesi can invade DARC-negative Macaca spp RBCs through alternative molecular interactions.6,9,11P falciparum, the most virulent of human malaria parasites, uses the sialic acid and the peptide components of glycophorin A,8 but it also has alternative pathways of invasion.20,21 Erythrocyte receptors for the alternative invasion pathways are unknown. The identity and function of erythrocyte receptors are important for 2 reasons. First, blocking these receptors provides a potential point of interference with the malaria life cycle. Indeed, blocking of DARC by various chemokines has been shown to prevent P knowlesiinvasion in vitro.22 Second, erythrocyte receptor specificity can be used to identify parasite erythrocyte-binding proteins, which are candidates for inclusion in multistage vaccines.
The nonlethal murine malaria parasite P yoelii 17X is one of the most widely used rodent models of malaria infection, but it has primarily been used for studying immunologic responses to the parasite. In previous studies we identified 2 congenic mouse strains (BALB/c and BALB.D2.Mlsa) with different susceptibility toP yoelii.23 These mice share their entire genome, with the exception of an approximately 20-kb region of chromosome 1.24 This region includes the gene encoding DARC.25 Little is known about the invasion pathways ofP yoelii, possibly because in vitro invasion assays have not been described. The research described in this report addresses the role of DARC in P yoelii invasion of erythrocytes. We use a novel in vivo invasion assay to demonstrate that the murine DARC is a receptor for P yoelii 17X. Our data show that the absence of DARC reduces normocyte (mature erythrocyte) invasion to negligible levels but affects reticulocyte (immature erythrocyte) invasion only slightly. These findings represent the first description of an erythrocyte receptor for P yoelii invasion and show the conservation of host-receptor interactions between rodent and human malarias. With our added understanding of the erythrocyte invasion mechanisms in P yoelii, we can better use this model for identifying how immunity can interfere with the invasion process and how the parasite determines host cell preference.
Materials and methods
Parasites
P yoelii (17X), used as a frozen stabilate, was obtained from Dr Peter Sayles, University of Wisconsin, and was originally obtained from Dr James Fahey at the Trudeau Institute.P chabaudi chabaudi was obtained from Dr William Weidanz at the University of Wisconsin-Madison.
Mice
Eight- to 12-week-old mice were used for all experiments. BALB/c mice were used as recipients for in vivo invasion assays and either were purchased from Jackson Laboratories or were bred at the Colorado State University. BALB/c mice were used because the high parasitemia they develop after P yoelii infection is optimal for measuring invasion into transfused erythrocytes (see sections referring to in vivo invasion assays). DARC homozygous knock-out (DKO)26 and wild-type (WT) mice were bred from heterozygous mice. Heterozygous mice were produced by breeding homozygous DKO males with homozygous WT females. All mice were maintained in the Painter Center of the Laboratory Animal Facility of Colorado State University.
Infections and hematologic evaluation
Mice were infected using an intraperitoneal inoculation of 106 parasitized RBCs obtained from a BALB/c source mouse infected 6 days earlier with a frozen parasite stabilate. Blood was obtained on days 3, 5, 7, 10, 14, and 21 or 25 days after infection by a tail snip. Parasitemia was determined by counting the number of parasitized RBCs in a total count of 300 to 500 RBCs on Wright-Giemsa–stained thin blood smears. The percentage of reticulocytes was determined by counting polychromatophilic RBCs on Wright-Giemsa–stained thin blood smears. The number of polychromatophilic RBCs correlates well with the number of reticulocytes counted on new methylene blue–stained smears (r = 0.93, linear regression). The percentage of normocytes infected was determined by counting the number of infected normochromic RBCs in a total of 300 normochromic RBCs. The percentage of reticulocytes infected was determined by counting the number of infected polychromatophilic RBCs in a total of 100 polychromatophilic RBCs. Figure 1 shows examples of each cell type counted in these analyses. Hematocrits were determined directly from centrifuged capillary tubes containing blood obtained from the tail vein by a tail nick.
Measuring infection of reticulocytes and normocytes.
Differential counts of erythrocyte types were performed by counting the number of infected normocytes (black arrow), uninfected normocytes (red arrow), infected reticulocytes (black arrowhead), and uninfected reticulocytes (red arrowhead). Original magnification, × 1000; stain, Wright-Giemsa.
Measuring infection of reticulocytes and normocytes.
Differential counts of erythrocyte types were performed by counting the number of infected normocytes (black arrow), uninfected normocytes (red arrow), infected reticulocytes (black arrowhead), and uninfected reticulocytes (red arrowhead). Original magnification, × 1000; stain, Wright-Giemsa.
In vivo invasion assay for measuring invasion of erythrocytes from normal mice
This assay measures the number of biotinylated RBCs from uninfected donor mice that are invaded after transfusion into P yoelii–infected recipient mice. Blood from donor mice (BALB/c, DKO, or WT, depending on the experiment) was obtained by cardiac puncture (after CO2 or isoflurane euthanasia) into citrate phosphate dextrose–adenine anticoagulant. RBCs were biotinylated as previously described.27 Briefly, whole blood was added directly to PBS (4 mL per mouse harvested) containing an N-hydroxy succinimide ester of biotin with an inserted 6-atom spacer (Biotin-X-NHS; Calbiochem, San Diego, CA) in dimethyl formamide (1.35 mg Biotin-X-NHS in 50 μL dimethyl formamide per mouse harvested). RBCs were incubated for 30 minutes at 37°C and were washed once in PBS. Recipient mice (BALB/cByJ) were infected with P yoeliior P chabaudi 5 days before transfusion so that the parasitemia rate was approximately 30% to 60% at the time of transfusion. Approximately 4 × 109 biotinylated RBCs from donor mice were transfused into recipient mice intraperitoneally in a total of 0.2 mL. Blood was removed from recipient mice at various times after transfusion and was incubated sequentially with streptavidin-phycoerythrin (SA-PE) (PharMingen, San Diego, CA) to detect transfused RBCs and thiazole orange (TO) (Sigma, St Louis, MO). TO is a permeant nucleic acid stain28 that detects parasitized RBCs and not the anucleate, uninfected, mature RBCs. Cells were analyzed on a Coulter EPICS XL (Coulter XL, Hialeah, FL). RBCs were gated based on the log of red fluorescence (biotinylated, transfused cells), and the percentage of biotinylated RBCs fluorescing green was then determined. The result gives the percentage of biotinylated, transfused cells that have been infected. Controls were cells from untransfused infected mice (no cells fluoresce red), donor cells (100% biotinylated, only 1%-3% TO positive because of reticulocytes), and an infected, transfused mouse incubated with only SA-PE or only TO.
In vivo invasion assay for measuring invasion of reticulocytes from phenylhydrazine- and erythropoietin-treated mice
Reticulocyte-rich blood was generated in donor mice by administering 1.5 mg phenylhydrazine (Sigma) IP for 2 days and then 4 U human recombinant erythropoietin (Epogen; Amgen, Thousand Oaks, CA) IP for 4 days. This resulted in a reticulocytosis of 58% to 72%, as determined by counting the number of polychromatophilic RBCs on Wright-Giemsa–stained thin blood smears. RBCs were harvested by cardiac puncture, biotinylated, and transfused into infected recipient BALB/c as described above. Because TO staining and flow cytometry do not distinguish an infected reticulocyte from an uninfected one (the RNA in reticulocytes binds TO), the percentage of invaded reticulocytes was microscopically determined on cytocentrifuge preparations of positively selected biotinylated RBCs as follows. Ten microliters blood was taken from each recipient mouse by tail snip and was pooled by group in 10 μL citrate phosphate dextrose-adenine anticoagulant. Biotinylated cells were separated from recipient cells in the pooled samples by positive selection using a magnetic column (MiniMacs; Miltenyi Biotec, Auburn, CA). Pooled RBCs (2 × 108) were incubated for 40 minutes with 10 μL magnetic streptavidin beads, washed, and allowed to flow through a magnetic column. Retained cells were eluted from the column by removal of the column from the magnet. Cytocentrifuge preparations were made from the retained cells for each strain of mouse. Blood from recipients was taken at 6 hours after transfusion because infected reticulocytes cannot be reliably identified microscopically at 24 hours (the parasite becomes so large that polychromatophilic cytoplasm cannot be detected in any infected RBCs). Recipient mice transfused with biotinylated normocytes (1%-3% reticulocytes) were used as controls in initial experiments. Table1 summarizes a typical enrichment of biotinylated cells and reticulocytes by this method.
Enrichment of transfused reticulocytes from recipient mice
| Source of blood . | Type of sample . | Reticulocytes, % . | Biotinylated, % . |
|---|---|---|---|
| BALB/c recipient-reticulocyte-rich cells transfused (6 h) | Blood smear | 4.63 | ND |
| Column retentate | 29.5 | 76.8 | |
| Column eluate | 1.8 | 6.5 | |
| BALB/c recipient-normocyte-rich cells transfused (6 h) | Blood smear | 1.13 | ND |
| Column retentate | 0.95 | 70.0 | |
| Column eluate | 1.6 | 16.0 |
| Source of blood . | Type of sample . | Reticulocytes, % . | Biotinylated, % . |
|---|---|---|---|
| BALB/c recipient-reticulocyte-rich cells transfused (6 h) | Blood smear | 4.63 | ND |
| Column retentate | 29.5 | 76.8 | |
| Column eluate | 1.8 | 6.5 | |
| BALB/c recipient-normocyte-rich cells transfused (6 h) | Blood smear | 1.13 | ND |
| Column retentate | 0.95 | 70.0 | |
| Column eluate | 1.6 | 16.0 |
Reticulocyte-rich blood from DKO or WT mice was biotinylated and transfused into 5-day P yoelii–infected BALB/c mice, and blood was sampled at 6 hours after transfusion. Reticulocytes were enumerated in cells positively selected by a magnetic column.
ND indicates not done.
Enzyme treatments of erythrocytes
For the experiments measuring the effects of enzymes on invasion, RBCs from normal BALB/c mice or reticulocyte-rich blood from phenylhydrazine- and erythropoietin-treated BALB/c mice were treated with chymotrypsin at 1 mg/mL (type VII, TLCK treated; Sigma, C3142), trypsin (type XI, DPCC treated; Sigma T1005) at 1 mg/mL, neuraminidase (normal blood only) (Sigma, N2876) at 50 U/mL, or PBS only for 1 hour at 37°C before in vivo invasion assay. These cells were washed 3 times in PBS, then biotinylated and transfused into infected BALB/c mice as described for the in vivo invasion assay.
Statistical analysis
Single-factor analysis of variance (ANOVA) for repeated measures with a Fisher PLSD post hoc test was performed to compare the parasitemia between strains of mice for P yoelii and P chabaudi at each time point after infection. Single-factor ANOVA was used to compare invasion of RBCs by P yoelii between DKO, heterozygote (HET), and WT RBCs at each time point after transfusion. Student t test was used to compare the P chabaudi invasion rate of RBCs between DKO and WT mice (when there were only 2 strains compared) and to compare enzyme treatments and controls for each time point after transfusion.
Results
P yoelii infection is less severe in DKO mice
We found previously23 that mice congenic for a region of chromosome 1 that contains DARC have a different susceptibility for P yoelii infection. Because DARC is the erythrocyte receptor for P vivax and P knowlesiand binds to a parasite protein conserved between these 2 species, we sought to determine whether DARC is a host receptor also used by rodent malarias. We infected DKO and WT mice with P yoeliior P chabaudi and measured parasitemia at days 3, 5, 7, 10, 14, and 21 or 25 after infection. By day 21 or 25 the infections had been cleared in both strains (data not shown). Figures2A and 2B show 2 representative experiments (out of 4) comparing the parasitemia of DKO with WT mice infected with P yoelii. Using ANOVA for repeated measures, we determined that the parasitemia of WT mice was significantly greater than that of DKO mice at days 5 through 14 after infection in these 2 experiments. Moreover, in 2 of 4 experiments, the packed cell volume was significantly lower in WT mice at day 7 of infection (data not shown). Thus, the course of P yoelii infection was more severe in WT mice than DKO mice. By comparison, there was no difference in parasitemia at any time point after infection in P chabaudi–infected mice in 2 different experiments (Figure 2C). The fact that there is parasite strain specificity indicates that the expression of DARC does not affect a more general aspect of malaria invasion, such as membrane fluidity, and that it plays a specific role in P yoelii infection. Our conclusion from these experiments is that DARC is an important molecule for P yoelii, but notP chabaudi, erythrocyte invasion.
DKO mice have reduced parasitemia in P yoelii infection.
Each graph represents one experiment. DKO or WT mice (6-10 per group) were infected intraperitoneally with 106 parasitized RBCs at day 0 (P yoelii or P chabaudi). Parasitemia was determined at specified days after infection by counting the number of parasitized RBCs in a total of at least 300 RBCs on Wright-Giemsa–stained thin blood smears. Data are represented as the mean ± SD. Significantly different groups (P < .05) are marked by an asterisk. (A, B) Mice infected with P yoelii. Parasitemia in WT mice was significantly greater than that of DKO mice at days 5 to 14 after infection. (C) Mice infected withP chabaudi. There was no difference between the strains in parasitemia.
DKO mice have reduced parasitemia in P yoelii infection.
Each graph represents one experiment. DKO or WT mice (6-10 per group) were infected intraperitoneally with 106 parasitized RBCs at day 0 (P yoelii or P chabaudi). Parasitemia was determined at specified days after infection by counting the number of parasitized RBCs in a total of at least 300 RBCs on Wright-Giemsa–stained thin blood smears. Data are represented as the mean ± SD. Significantly different groups (P < .05) are marked by an asterisk. (A, B) Mice infected with P yoelii. Parasitemia in WT mice was significantly greater than that of DKO mice at days 5 to 14 after infection. (C) Mice infected withP chabaudi. There was no difference between the strains in parasitemia.
P yoelii invades WT erythrocytes more efficiently than DKO erythrocytes
The Duffy glycoprotein is a receptor for chemokines; therefore, its absence could affect the outcome of an immune response.26 To establish that DKO mice were more resistant to P yoelii infection because of the receptor function of this protein, we developed a short-term in vivo invasion assay that allowed us to examine the rate of invasion of DKO and WT erythrocytes independently of the immune response. Parasite invasion rates were determined by biotinylating erythrocytes from DKO or WT mice and transfusing them into P yoelii–infected BALB/c mice with a high parasitemia (30%-60%). Whole blood from recipient mice, sampled 24 and 48 hours after transfusion, was stained with SA-PE to detect transfused cells and with thiazole orange to stain parasitized RBCs. The percentage of transfused RBCs invaded was measured by flow cytometry. Figure 3A shows that the invasion rate of WT RBC was 7.5-fold greater than that of the DKO RBCs at 24 hours and 8.5-fold greater at 48 hours. The invasion rate of heterozygotes was intermediate between the 2 groups and was significantly different from both. Figure 3B shows that this difference in invasion rate was specific for P yoelii because there was no difference in the ability of P chabaudi to invade DKO and WT erythrocytes at either time point after transfusion. These results indicate that some portion of the invasion process is inhibited by the lack of DARC expression. The data also show that though DARC is critical for maximal invasion of RBCs, there is also a Duffy-independent pathway of invasion; a small percentage (5%-6%) of DKO RBCs is invaded by P yoelii.
WT erythrocytes are invaded more efficiently than DKO erythrocytes.
Each graph is representative of 2 identical experiments. (A) RBCs from DKO, HET, or WT mice were biotinylated and transfused into BALB/c mice infected with P yoelii to measure the parasite invasion rate using the in vivo invasion assay. Recipient mice were bled at 24 and 48 hours after transfusion. Data are presented as the mean and standard deviation of the percentage of transfused cells that are thiazole orange positive. The invasion rate of P yoelii is significantly greater in the WT-type RBCs than in DKO RBCs or HET RBCs. Groups with different letters are significantly different from each other (P < .0001). (B) In a separate experiment, the invasion rate of P chabaudi at 24 and 48 hours was measured in DKO and WT RBCs. There is no difference in invasion rate between the groups at either time point after infection.
WT erythrocytes are invaded more efficiently than DKO erythrocytes.
Each graph is representative of 2 identical experiments. (A) RBCs from DKO, HET, or WT mice were biotinylated and transfused into BALB/c mice infected with P yoelii to measure the parasite invasion rate using the in vivo invasion assay. Recipient mice were bled at 24 and 48 hours after transfusion. Data are presented as the mean and standard deviation of the percentage of transfused cells that are thiazole orange positive. The invasion rate of P yoelii is significantly greater in the WT-type RBCs than in DKO RBCs or HET RBCs. Groups with different letters are significantly different from each other (P < .0001). (B) In a separate experiment, the invasion rate of P chabaudi at 24 and 48 hours was measured in DKO and WT RBCs. There is no difference in invasion rate between the groups at either time point after infection.
DKO normocytes but not reticulocytes are resistant to P yoelii infection in vivo
We made 2 observations from the infection experiments represented in Figure 2. The first is that DKO mice could be infected, though at a low parasitemia level, by P yoelii. We therefore considered the possibility that an alternative or additional receptor to DARC must be expressed by a small subpopulation of host erythrocytes. The second is that the lower rate of parasitemia in the DKO mice was most dramatic at days 5 and 7 after infection, when reticulocytes are rare in the circulation, but was less evident at later days of infection, when there is a surge of circulating reticulocytes in both strains (Figure4A-B). In fact, parasitemia of the DKO and WT mice was not statistically different when only days 10 and 14 were analyzed using ANOVA for repeated measures (data not shown). The influx of reticulocytes into the circulation in response to anemia begins at day 10 and corresponds to a drop in the difference in parasitemia between WT and DKO mice (Figure 4B). We hypothesized that the alternative or additional receptor for P yoelii exists on reticulocytes and young normocytes. To elucidate this, we compared the percentages of normocytes or reticulocytes infected in each strain in the early days of infection (days 3-7), before the marked increase in circulating reticulocytes (few normocytes were infected at days 10 and 14, making comparisons at these time points difficult). Figure5A shows one representative experiment that reveals that the percentages of normocytes infected at days 5 and 7 are significantly higher (P < .05) for WT mice than for DKO mice. The normocyte parasitemia for the WT mice was 3.7-fold greater on day 5 and 11.2-fold higher on day 7 in this experiment. Figure 5B shows that the percentages of reticulocytes infected at days 3, 5, and 7 after infection in this experiment were not different between the strains and that the reticulocyte infection rate is much higher than the normocyte rate (between 66% and 100% for reticulocytes vs 1.5% and 20% for normocytes in DKO and WT mice, respectively). This analysis leads to 2 conclusions. The first is that reticulocytes are invaded more efficiently than normocytes, in spite of the fact that they exist as a small percentage of the total erythrocyte population. The second is that, though there is a large difference inP yoelii infection of DKO and WT normocytes, there is no difference in the infection of reticulocytes. We hypothesized that although DARC is the primary receptor for normocytes, an alternative or additional receptor for P yoelii is expressed on reticulocytes.
The difference in parasitemia between
P yoelii–infected DKO and WT mice decreases when reticulocytes enter the circulation. Data shown are derived from one representative infection experiment and are presented as the mean of 6 infected mice in each group. (A) There is a dramatic increase in the percentage of circulating reticulocytes beginning at day 10 after infection. (B) This corresponds to a drop in the fold difference in parasitemia from 4.8 (day 7) to 1.6 (day 10).
The difference in parasitemia between
P yoelii–infected DKO and WT mice decreases when reticulocytes enter the circulation. Data shown are derived from one representative infection experiment and are presented as the mean of 6 infected mice in each group. (A) There is a dramatic increase in the percentage of circulating reticulocytes beginning at day 10 after infection. (B) This corresponds to a drop in the fold difference in parasitemia from 4.8 (day 7) to 1.6 (day 10).
P yoelii infection of normocytes and reticulocytes in vivo.
Wright-Giemsa–stained thin blood smears from P yoeliiexperiment 1 (Figure 2) were recounted, and the percentage of total normocytes infected or the percentage of total reticulocytes infected was calculated (see “Materials and methods”). Each data point represents the mean ± SD. Significance (P < .05) is represented by asterisks. (A) The percentage of normocytes infected. (B) The percentage of reticulocytes infected. In the absence of the Duffy antigen, P yoeliiparasites are significantly impaired in their ability to invade normocytes and to preferentially invade reticulocytes.
P yoelii infection of normocytes and reticulocytes in vivo.
Wright-Giemsa–stained thin blood smears from P yoeliiexperiment 1 (Figure 2) were recounted, and the percentage of total normocytes infected or the percentage of total reticulocytes infected was calculated (see “Materials and methods”). Each data point represents the mean ± SD. Significance (P < .05) is represented by asterisks. (A) The percentage of normocytes infected. (B) The percentage of reticulocytes infected. In the absence of the Duffy antigen, P yoeliiparasites are significantly impaired in their ability to invade normocytes and to preferentially invade reticulocytes.
WT and DKO reticulocytes are invaded with almost equal efficiency
To explore whether reticulocyte invasion by P yoelii is independent of DARC, we measured the invasion rate of reticulocytes from DKO or WT mice using the in vivo invasion assay. This assay, using donor blood from normal mice, measures the invasion rate of normocytes primarily because only 1% to 3% of circulating RBCs are reticulocytes. We will, therefore, refer to RBCs from normal mice as normocytes. Because uninfected reticulocytes cannot be distinguished from infected reticulocytes or infected normocytes using thiazole orange and flow cytometry, the percentage of transfused reticulocytes that became infected was determined microscopically. Transfused reticulocytes were enriched from peripheral blood samples of recipient mice by streptavidin beads and a magnetic column. Figure6 shows that the percentage of transfused infected WT reticulocytes was only 1.35- to 1.4-fold greater than the percentage of transfused infected DKO reticulocytes at 6 hours after transfusion. Given that most of the WT reticulocytes were infected at 6 hours after infection, it is unlikely that this difference will increase at future time points. This is markedly less than the 7.5-fold increase in infection rate of WT normocytes compared with DKO normocytes seen at 24 hours after transfusion. To compare this to the invasion rate of normocytes, we, in one experiment, also measured the invasion rate of normocytes at 6 hours. At this time, 2.7% of the DKO normocytes were infected compared with 7.27% of the WT normocytes (2.7-fold difference, P = .03). This difference increases to 8.5-fold by 48 hours in the normocyte invasion experiments. We concluded from these data that there is a DARC-independent pathway for reticulocyte invasion. The small increase in invasion in WT reticulocytes may be explained by the presence of DARC on WT reticulocytes.
P yoelii invades reticulocytes with almost equal efficiency.
Reticulocyte-rich blood from DKO or WT mice was biotinylated and transfused into 4 BALB/c mice infected with P yoelii to measure the parasite invasion rate using the in vivo invasion assay. Each of 2 experiments is represented on the graph. Recipient mice were bled at 6 hours after transfusion, and the blood from mice of each group was pooled. Biotinylated cells were positively selected by a magnetic column using streptavidin-coated beads. Percentages of reticulocytes invaded were determined by counting the percentage of reticulocytes infected on Wright-Giemsa–stained cytocentrifuge preparations of the biotin-positive RBCs. Numbers above the bars represent the fold difference in invasion rate.
P yoelii invades reticulocytes with almost equal efficiency.
Reticulocyte-rich blood from DKO or WT mice was biotinylated and transfused into 4 BALB/c mice infected with P yoelii to measure the parasite invasion rate using the in vivo invasion assay. Each of 2 experiments is represented on the graph. Recipient mice were bled at 6 hours after transfusion, and the blood from mice of each group was pooled. Biotinylated cells were positively selected by a magnetic column using streptavidin-coated beads. Percentages of reticulocytes invaded were determined by counting the percentage of reticulocytes infected on Wright-Giemsa–stained cytocentrifuge preparations of the biotin-positive RBCs. Numbers above the bars represent the fold difference in invasion rate.
Chymotrypsin, but neither trypsin nor neuraminidase treatment, eliminates the invasion of P yoelii into BALB/c normocytes
Determining the enzyme sensitivity of invasion or of the binding of parasite erythrocyte-binding proteins is useful for preliminary characterization of the receptor–ligand interaction.4,6,16,29-31 For instance, treating human RBCs with chymotrypsin, which eliminates Duffy, but not trypsin or neuraminidase, eliminates the invasion of human RBCs by P vivax and P knowlesi,6,15 30 and this correlates with the elimination of the binding of their respective Duffy-binding proteins. To initially characterize the P yoelii normocyte receptor, we digested BALB/c RBCs with chymotrypsin, trypsin, and neuraminidase. We found that chymotrypsin treatment eliminated P yoelii normocyte invasion, whereas trypsin or neuraminidase had no effect (Figure7). This indicated that the Duffy receptor had the same enzyme sensitivity to P yoeliiinvasion as the human Duffy glycoprotein. This will allow us to compare invasion sensitivity to the erythrocyte-binding protein sensitivity of candidate erythrocyte-binding proteins and enabled us to compare the enzyme sensitivity of the reticulocyte receptor.
Chymotrypsin eliminates the invasion of P yoelii into murine normocytes.
RBCs from normal BALB/c mice were treated with chymotrypsin (1 mg/mL), trypsin (1 mg/mL), neuraminidase (50 U/mL), or buffer only, and the invasion rate was measured using in vivo invasion assay. Data are reported as the mean ± SD of thiazole orange–positive transfused cells. Significant difference (P < .05) is represented by an asterisk. Invasion was eliminated in chymotrypsin-treated RBCs.
Chymotrypsin eliminates the invasion of P yoelii into murine normocytes.
RBCs from normal BALB/c mice were treated with chymotrypsin (1 mg/mL), trypsin (1 mg/mL), neuraminidase (50 U/mL), or buffer only, and the invasion rate was measured using in vivo invasion assay. Data are reported as the mean ± SD of thiazole orange–positive transfused cells. Significant difference (P < .05) is represented by an asterisk. Invasion was eliminated in chymotrypsin-treated RBCs.
Reticulocyte invasion is sensitive to chymotrypsin and trypsin treatment
The difference in reticulocyte invasion rate between DKO and WT mice was smaller than the difference in normocyte invasion rate between the 2 strains. We hypothesized that P yoelii uses a receptor different from DARC to infect reticulocytes. To initially characterize the P yoelii reticulocyte receptor and to compare its enzyme sensitivity with normocyte receptor enzyme sensitivity, we digested reticulocyte-rich BALB/c RBCs with chymotrypsin and trypsin before the in vivo invasion assay. Invasion of reticulocytes was measured microscopically after isolation of the biotinylated reticulocytes on a magnetic column. Both enzymes almost completely eliminated P yoelii invasion of reticulocytes (Figure8). P yoelii invaded the trypsin-treated reticulocytes 3-fold more frequently than the chymotrypsin-treated reticulocytes. We speculate that this is because DARC is not removed by trypsin and that it can, therefore, remain as a receptor for P yoelii invasion. This preliminary characterization of the reticulocyte receptor gave further evidence that it is different from DARC and is, therefore, an alternative receptor for P yoelii invasion.
Reticulocyte invasion is sensitive to chymotrypsin and trypsin treatment.
Reticulocyte-rich blood from normal BALB/c mice was treated with chymotrypsin (1 mg/mL), trypsin (1 mg/mL), or buffer alone, and the invasion rate of P yoelii was measured using the in vivo reticulocyte invasion assay as described in “Materials and methods.” The experiment was performed twice, and the data reported are representative of both experiments. Invasion of reticulocytes was almost eliminated by chymotrypsin and trypsin.
Reticulocyte invasion is sensitive to chymotrypsin and trypsin treatment.
Reticulocyte-rich blood from normal BALB/c mice was treated with chymotrypsin (1 mg/mL), trypsin (1 mg/mL), or buffer alone, and the invasion rate of P yoelii was measured using the in vivo reticulocyte invasion assay as described in “Materials and methods.” The experiment was performed twice, and the data reported are representative of both experiments. Invasion of reticulocytes was almost eliminated by chymotrypsin and trypsin.
Discussion
Our results offer several novel findings. First, we have found that DARC is the erythrocyte receptor for P yoelii. Our data showed that there was reduced parasitemia in DKO mice compared with WT mice. Because differences in parasitemia can certainly be attributed to immunologic differences between 2 closely related strains of mice, we developed the in vivo invasion assay to determine the invasion rate, independent of any immunologic factors, of P yoelii into DKO or WT normocytes. Our data showed conclusively that there is a marked reduction in invasion rate of P yoelii into RBCs when DARC is not expressed. To ensure that the lack of DARC expression did not affect a general physical aspect of RBCs that might have altered invasion, we measured the invasion rate of a different murine malaria parasite, P chabaudi. P chabaudi showed no invasion rate difference between DKO and WT RBCs, indicating that DARC is a receptor specific to P yoelii.
Our data also showed that there is a DARC-independent pathway for reticulocyte invasion. We first suspected this when P yoeliiinfection of DKO and WT mice revealed that although the lack of DARC lowered parasitemia, there was still a low level of parasitemia in DKO mice. This indicated that a small subpopulation of erythrocytes can become infected with P yoelii regardless of DARC expression. We also noted that the biggest difference in parasitemia between the 2 strains appeared early in infection, when reticulocytes are rare in the circulation. We speculated that the small subpopulation of erythrocytes consisted of reticulocytes and young normocytes. We confirmed that there is a DARC-independent pathway of invasion by showing that DKO and WT reticulocytes are invaded by P yoelii at similar rates. Furthermore, normocyte invasion was eliminated with chymotrypsin only, whereas reticulocyte invasion was sensitive to chymotrypsin and trypsin.
The parasite ligand for the murine DARC has not been described, although 3 erythrocyte-binding proteins have been identified forP yoelii. A 235-kd and a 135-kd erythrocyte binding protein have been described for P yoelii 17X using standard erythrocyte-binding assays.31,32 The amino cysteine-rich domains of MAEBL, a chimeric protein that has homology to the apical membrane antigen-1, bind erythrocytes when expressed in a mammalian cell line.7 Current information points to p135 as the most likely candidate for the Duffy-binding protein. This is based on our finding that DARC-dependent (normocyte) P yoelii invasion is sensitive to chymotrypsin only, and a recent study shows that the binding of p135 is sensitive to chymotrypsin only.31 The preference of p135 for binding to reticulocytes or normocytes is not yet known. Determining in a standard erythrocyte-binding assay that this protein binds to WT RBCs and not to DKO RBCs will clearly identify this molecule as the Duffy-binding protein. Erythrocyte binding of the 235-kd rhoptry protein31 and MAEBL (John H. Adams, personal communication, May 2001) is sensitive to chymotrypsin and trypsin. Discovery of this makes these proteins candidates for the reticulocyte receptor ligand of P yoelii because we found that the invasion of P yoelii is sensitive to both these enzymes. This is interesting considering that p235 contains sequences with significant homology to a region of the reticulocyte binding protein 2 of P vivax.5,33 However, there is conflicting evidence from other studies that p235 is more likely a normocyte receptor, not a reticulocyte receptor. For instance, the binding of p235 is greater on mature erythrocytes,31 and antibodies to this protein administered to infected mice transformP yoelii YM from a normocyte-infective parasite to a reticulocyte-restricted one.34,35 Given that p235 is part of a large gene family,36 it is possible that family members differ in their binding specificity. This may be why antibody blockade studies and our enzyme sensitivity studies contradict each other.
Erythrocyte receptors for malaria parasites have been used to identify erythrocyte-binding proteins thought to be critical for invasion.4,6,8,9,15 Once the erythrocyte receptor and its parasite ligand are known, the structural interactions critical for receptor and ligand binding can be determined. Although murine parasite proteins that bind to erythrocytes have been identified,7,29,31,32,37,38 this initial description of an erythrocyte receptor used by murine malaria parasites for invasion will bring us closer to an understanding of the structural interactions involved in invasion. The human DARC is a promiscuous chemokine receptor expressed on erythrocytes, postcapillary endothelial venules, vascular endothelial cells, and epithelial cells in nonerythroid organs and Purkinje cells in the cerebellum.19,39-41 The murine DARC gene is syntenic to the human gene. It has 60% amino acid homology to the human protein, and it is similar in structure and function.25 We have shown that P yoelii, likeP knowlesi and P falciparum, has multiple pathways of invasion. Hence, P vivax appears to be in the minority of commonly studied parasites in that its invasion capability is dependent on only one molecule. The presence of alternative pathways of invasion may confer a selective advantage for malaria, and it confounds efforts to develop a strategy to block invasion by blocking a single molecular interaction. Differences between Plasmodiumspecies in their invasion efficiency may reflect the presence or absence of additional receptors that support alternative pathways of invasion. For instance, P vivax may possess the minimum number of receptors required for invasion, so that if one is lost or inactivated (for example, during reticulocyte maturation to erythrocytes), invasion is blocked. Other parasites may have expansion of erythrocyte-binding protein families that allow them to invade normocytes.
The discovery that there is a DARC-independent pathway for reticulocyte invasion provides a model for dissecting the mechanisms of host–cell preference (reticulocyte vs normocyte). This is an important goal because reticulocytotropic strains tend to cause less severe disease than those that have the capability of invading both subsets of erythrocytes.42 Our findings in our infection and invasion experiments show that P yoelii invades reticulocytes more efficiently than normocytes, regardless of mouse strain examined. It has been argued that special receptors exist to facilitate reticulocyte invasion because they are present in such small numbers in the peripheral blood.5,43 Indeed, reticulocyte-specific parasite proteins have been defined for the reticulocyte-restrictedP vivax and P cynomolgi.5Although no specific reticulocyte-binding proteins have been found forP yoelii,31 our findings show that reticulocytes are more efficiently invaded. This suggests that the redundancy of receptors in P yoelii allows more efficient invasion of reticulocytes than normocytes and that perhaps reticulocyte-specific receptors expressed by P yoelii are not detected by standard erythrocyte-binding assays. As the ability to invade normocytes enhances virulence, determining which interactions are essential for normocyte invasion may be more critical for developing approaches for ameliorating disease. Understanding what receptor–ligand interactions are important for normocyte invasion may also allow us to estimate the likelihood that a low virulence reticulocytotropic parasite (such asP vivax) may evolve into a more virulent parasite that can affect all erythrocyte maturational stages.
P vivax and P knowlesi use DARC as a receptor for human erythrocyte invasion through specific Duffy-binding microneme proteins.3,6,9-13,15,16,18 Although P falciparumdoes not use DARC as a receptor, its major erythrocyte-binding protein belongs to the same family as the P vivax andP knowlesi Duffy-binding proteins.3 8Erythrocyte-binding proteins are conserved between malaria species. Our findings show that the use of DARC as an erythrocyte receptor is also conserved among murine, human, and simian species of malaria. This prepares us to identify the P yoelii DARC ligand, the reticulocyte receptor, and the parasite ligand for the reticulocyte receptor. Identification of these structures and their function in invasion are important for the future use of the P yoeliimodel in the design and testing of immunologic or pharmacologic interventional strategies.
We thank Rachel Keller and Angie Marolf for excellent technical assistance; Dr John Adams for scientific input; Dr Joseph Smith for many stimulating discussions and for critically reviewing the manuscript; and Drs Roland and Mary Anne Swardson for critically reviewing the manuscript.
Supported by National Institutes of Health grants AI42351 (A.C.A.), AI01724-02 (C.J.S.-O.), GM20069 (N.M.), and HL42630 (N.M.).
The publication costs of this article were defrayed in part by page charge payment. Therefore, and solely to indicate this fact, this article is hereby marked “advertisement” in accordance with 18 U.S.C. section 1734.
References
Author notes
Christine Jay Swardson-Olver, Department of Pathology, College of Veterinary Medicine and Biomedical Sciences, Colorado State University, Fort Collins, CO 80523; e-mail:christine.olver@colostate.edu.

This feature is available to Subscribers Only
Sign In or Create an Account Close Modal